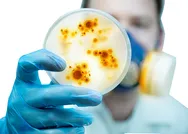

Londra, potansiyel koronavirüs aşısı için 60 milyon dozluk yeni sipariş verdi
İngiliz Hükümeti ile Fransız ilaç şirketi Sanofi ve İngiliz ilaç şirketi GlaxoSmithKline arasında, iki şirket tarafından geliştirilen potansiyel Kovid-19 aşısından 60 milyon adet tedarik edilmesi konusunda anlaşmaya varıldı. Londra daha önce de Alman ilaç şirketi BioNTech ile 30 milyon doz, Fransız ilaç şirketi Valvena'yla ile de 60 milyon doz için anlaşma sağlamıştı.
Giriş Tarihi: Güncelleme Tarihi:

Şirketlerden yapılan ortak açıklamada, halen test süreci devam eden aşı çalışmasının başarılı olması halinde İngiliz hükümetine 60 milyon doz aşını tedarik edilmesi konusunda tarafların anlaştığı kaydedildi.
Açıklamada, İngiliz hükümetinin ödeyeceği meblağ belirtilmezken, aşı çalışmasının başarılı olması halinde denetim kuruluşları tarafından onay sürecinin 2021 yılının ilk yarısında tamamlanabileceği ifade edildi.
İngiliz hükümeti daha önce de Kovid-19 için geliştirilen ve henüz test aşamasında olan aşılar için Alman ilaç şirketi BioNTech ve Amerikan ilaç şirketi Pfizer ile 30 milyon doz için, Fransız ilaç şirketi Valvena'yla ile de 60 milyon doz için anlaşmıştı.